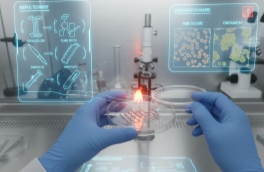
VR-симулятор «Эффективное животноводство и современные корма» VR-симулятор «Эффективное животноводство и современные корма»

VR-симулятор «Эффективное животноводство и современные корма»
Код товара: 232606
- Визуализация в 3D
- Фото
- Видео
Зажмите и перетаскивайте курсор в нужном направлении для вращения объекта
Зажмите и двигайте в нужную сторону

Цена по запросу
Цена указана для физических лиц. Цену при безналичном расчете уточняйте у менеджеров магазина.


 VR-симулятор «Цветоводство и тепличные технологии»VR-симулятор «Цветоводство и тепличные технологии»
VR-симулятор «Цветоводство и тепличные технологии»VR-симулятор «Цветоводство и тепличные технологии»
 VR-симулятор «Биотехнологии и пищевое производство»VR-симулятор «Биотехнологии и пищевое производство»
VR-симулятор «Биотехнологии и пищевое производство»VR-симулятор «Биотехнологии и пищевое производство»
 VR-симулятор «Аквакультура и рыболовство»VR-симулятор «Аквакультура и рыболовство»
VR-симулятор «Аквакультура и рыболовство»VR-симулятор «Аквакультура и рыболовство»
 VR-симулятор «Современные технологии пчеловодства»VR-симулятор «Современные технологии пчеловодства»
VR-симулятор «Современные технологии пчеловодства»VR-симулятор «Современные технологии пчеловодства»
 VR-комплекс «Птицеводство будущего: технологии и управление»VR-комплекс «Птицеводство будущего: технологии и управление»
VR-комплекс «Птицеводство будущего: технологии и управление»VR-комплекс «Птицеводство будущего: технологии и управление»
 VR-симулятор «Генетика и селекция растений»VR-симулятор «Генетика и селекция растений»
VR-симулятор «Генетика и селекция растений»VR-симулятор «Генетика и селекция растений»
Доставка:
Техническая консультация: бесплатно
Доставка по России: да
Производитель
 Россия
— родина бренда
Россия
— родина бренда Россия
— страна производства
Россия
— страна производства
Описание
Характеристики
Комплектация
Видео
Отзывы
Инновационная платформа виртуальной реальности для подготовки специалистов агропромышленного комплекса нового поколения
Образовательный VR-комплекс «Эффективное животноводство и современные корма» представляет собой многофункциональную симуляционную среду, разработанную для углубленного изучения современных технологий в области животноводства, ветеринарии и управления сельскохозяйственным производством. Продукт создан в рамках государственной программы развития агроклассов при участии специалистов Московского физико-технического института (МФТИ).
Модуль «Ветеринар и его деятельность» (для учащихся 8-11 классов)
Интерактивный симулятор, погружающий учащихся в профессиональную деятельность ветеринарного врача. Виртуальная среда позволяет отрабатывать практические навыки работы с сельскохозяйственными животными без риска для здоровья и благополучия реальных животных.
Учащийся выполняет комплекс стандартных ветеринарных процедур: проводит визуальный осмотр животного, измеряет температуру тела с помощью цифрового термометра, выполняет введение виртуальной вакцины, осуществляет обработку раневых поверхностей. Симулятор детально воспроизводит анатомические особенности животных, патологические изменения и реакции на медицинские вмешательства.
Модуль «Молочная ферма» (для 7-11 классов)
Уникальная образовательная среда для знакомства с современными технологиями молочного животноводства. Учащийся виртуально участвует в производственном процессе современной фермы: организует кормление коров с учетом рационов и норм кормления, управляет процессом доения на роботизированной установке, проводит оценку качества молока по органолептическим и физико-химическим показателям.
Симулятор демонстрирует взаимосвязь между качеством кормления, условиями содержания и продуктивностью животных. Учащийся изучает принципы работы автоматизированных систем управления микроклиматом, контроля над здоровьем стада и учета продуктивности.
Модуль «Виртуальный живой уголок» (для 8-11 классов)
Комплексный тренажер для моделирования логистических процессов и ветеринарного контроля на животноводческом комплексе. Учащийся организует движение животных по принципу «пусто-занято», устанавливает санпропускники и дезинфекционные барьеры, проводит плановые осмотры поголовья по утвержденному протоколу, реализует мероприятия по предотвращению распространения инфекционных болезней.
Модуль формирует системное понимание биобезопасности животноводческих предприятий, принципов зоогигиены и профилактической ветеринарии.
|
Пакет
|
Количество сценариев
|
Количество VR-шлемов
|
Стоимость (₽)
|
|---|---|---|---|
|
Минимум
|
3 сценария
|
2 VR-шлема
|
400 000 ₽
|
|
|
|
4 VR-шлема
|
748 000 ₽
|
|
|
|
6 VR-шлемов
|
1 044 000 ₽
|
|
|
|
8 VR-шлемов
|
1 319 200 ₽
|
|
Стандарт
|
6 сценариев
|
2 VR-шлема
|
530 000 ₽
|
|
|
|
4 VR-шлема
|
982 000 ₽
|
|
|
|
6 VR-шлемов
|
1 356 000 ₽
|
|
|
|
8 VR-шлемов
|
1 605 200 ₽
|
|
Плюс
|
9 сценариев
|
2 VR-шлема
|
647 000 ₽
|
|
|
|
4 VR-шлема
|
1 192 600 ₽
|
|
|
|
6 VR-шлемов
|
1 636 800 ₽
|
|
|
|
8 VR-шлемов
|
1 918 760 ₽
|
|
Максимум
|
21 сценарий (все 7 разделов)
|
2 VR-шлема
|
959 000 ₽
|
|
|
|
4 VR-шлема
|
1 754 200 ₽
|
|
|
|
6 VR-шлемов
|
2 385 600 ₽
|
|
|
|
8 VR-шлемов
|
2 754 920 ₽
|
Педагогические преимущества
- Безопасность обучения — отработка сложных производственных и ветеринарных операций без риска для здоровья учащихся, животных и оборудования
- Наглядность процессов — визуализация биохимических реакций, физиологических процессов и технологических операций, недоступных для прямого наблюдения в реальных условиях
- Экономическая эффективность — замена дорогостоящего лабораторного оборудования, расходных материалов и выездных практических занятий
- Повышение мотивации — игровые механики, эффект погружения и возможность самостоятельно принимать решения с мгновенной обратной связью
- Формирование практических компетенций — отработка навыков до уровня автоматизма перед работой с реальными животными
Технические характеристики и параметры
| Тип | Программа |
| Интерфейсы подключения | Облачный сервис |
Комплектация
| Программное обеспечение | VR-симулятор «Эффективное животноводство и современные корма» |
| Руководство пользователя | Да |




 Курс Биология. Цитология VR (бессрочная лицензия на 1 устройство)
70000 ₽
VR-комплекс «Биология Цитология VR» – это интерактивный образовательный инструмент, в рамках которого можно в наглядной форме «погрузиться» в строение клеток.
Курс Биология. Цитология VR (бессрочная лицензия на 1 устройство)
70000 ₽
VR-комплекс «Биология Цитология VR» – это интерактивный образовательный инструмент, в рамках которого можно в наглядной форме «погрузиться» в строение клеток.
Купить в один клик
Добавить в корзину
New



 Курс физики в VR «Магнетизм» (бессрочная лицензия)
55000 ₽
Курс физики в VR «Магнетизм» (бессрочная лицензия)
Курс физики в VR «Магнетизм» (бессрочная лицензия)
55000 ₽
Курс физики в VR «Магнетизм» (бессрочная лицензия)
Купить в один клик
Добавить в корзину
New



 Виртуальная лаборатория по химии (VR Chemistry Lab) (лицензия на 1 год)
50000 ₽
Виртуальная лаборатория по химии (VR Chemistry Lab) (лицензия на 1 год)
Виртуальная лаборатория по химии (VR Chemistry Lab) (лицензия на 1 год)
50000 ₽
Виртуальная лаборатория по химии (VR Chemistry Lab) (лицензия на 1 год)
Купить в один клик
Добавить в корзину
New

 VR-тренажер «Публичные выступления»
490000 ₽
VR-тренажер «Публичные выступления»
490000 ₽
Купить в один клик
Добавить в корзину








